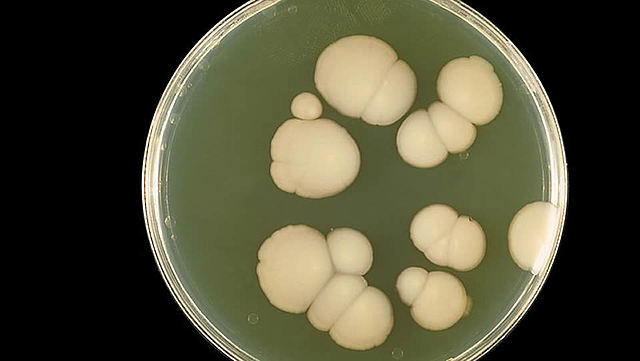
Julius Richard Petri

-
Micrographia (1665), el primer libro dedicado a las observaciones
microscópicas,Robert Hooke ilustró, entre otras muchas cosas, los
cuerpos fructificantes de los mohos. Fue la primera
descripción conocida de un microorganismo. -
-
Considerado el padre de la microbiologia, pudo observar bacterias. Las descubrió en 1676 mientras estudiaba infusiones de pimienta.
-
Se publican los descubrimientos de Antoni van Leeuwenhoek. La prestigiosa Royal Society de Londres,que las publicó en inglés en 1684.
-
científico germano-polaco. Cohn(1828-1898) era botánico, y su interés por la microscopía le llevó a estudiar las algas unicelulares y las bacterias, entre ellas Beggiatoa, una bacteria del azufre de gran tamaño. estaba especialmente interesado en la resistencia
de las bacterias al calor, y descubrió la formación de endosporas por parte de bacterias. Sentó las bases de un sistema de clasificación bacteriana, y concibió métodos para prevenir la
contaminación de los medios de cultivo -
Louis Pasteur, se opuso al postulado de la generación espontanea y en 1864, replicó la objeción de quienes lo criticaban de manera sencilla y brillante mediante la construcción de un matraz de «cuello de cisne», que hoy se conoce como matraz de Pasteur. En este matraz se podía calentar hasta ebullición la solución nutritiva y esterilizarla. La curva en el cuello impedía que la materia particulada (como los microorganismos) entrara en la solución nutritiva e iniciara la putrefacción.
-
-
Culmina su investigación sobre la tuberculosis, encontrando la causa de la misma.
-
El trabajode Pasteur sobre la rabia fue su mayor éxito, y culminó en juliode 1885 con la administración de la primera vacuna contra la
rabia a un ser humano, un joven francés llamado Joseph Meister
a quien había mordido un perro rabioso. En aquella época, la mordedura de un animal rabioso era mortal de necesidad. -
Es el creador de la Placa de Petri, un pequeño recipiente que permitió el estudio de cultivos puros.
-
La fama de Pasteur por su investigación de la rabia se hizo
legendaria y llevó al gobierno francés a fundar el Instituto
Pasteur en París en 1888 (Figura 1.18b). Inicialmente se creó
como una clínica para el tratamiento de la rabia y otras enfermedades contagiosas, pero hoy en día el Instituto Pasteur es
un importante centro de investigación biomédica cuyo objetivo
principal es la investigación y producción de antisuero y
vacunas. -
Winogradsky estaba especialmente interesado en las bacterias
que usan compuestos de nitrógeno y azufre, como las bacterias nitrificantes y las bacterias del azufre (Figura 1.24). Demostró
que estas bacterias catalizan transformaciones químicas específicas en la naturaleza, y propuso el importante concepto de
quimiolitotrofia, la oxidación de compuestos inorgánicos para
obtener energía. -
-
La mayor contribución de Beijerinck al campo de la
microbiología fue su clara formulación de la técnica del cultivo
de enriquecimiento. En ese tipo de cultivos, los microorganismos
se aíslan de muestras naturales mediante nutrientes
y condiciones de incubación muy selectivos para favorecer un
grupo metabólico concreto de organismos. -
a partir de aquí la microbiologia experimento un gran impulso debido al estudio de las propiedades genéticas de los microorganismos. (genomica)
Looking for a timeline maker?
Create timelines for projects, roadmaps, history, lessons, legal cases, and stories with Timetoast. Timetoast is a timeline maker for work, school, research, and stories.